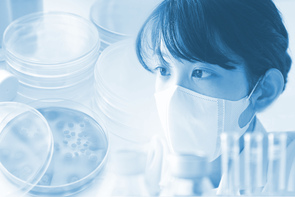
韓国、車に乗ったまま10分で検査が終わる「ドライブスルー検査」を実施-新型コロナウイルスの新しい検査方法-

- シンクタンクならニッセイ基礎研究所 >
- レポート >
- 経済 >
- アジア経済
アジア経済
「アジア・新興国経済」の一覧では、韓国、台湾、マレーシア、タイ、インドネシア、フィリピン、インド等成長を続ける主要アジア新興国・地域の実体経済、インフレ、金融政策の動向につき月次でレポートを行い、四半期毎に各国のGDPについて詳細な解説と先行きの見通しを提供します。また、アジア主要都市のオフィス市場、REIT市場等のアジアの不動産市場の現状について現地調査を踏まえた分析を行います。
年度で絞り込む
-
2020年03月10日
韓国政府、新型コロナ対策に31.7兆ウォン(約2.9兆円)の財源を投入
韓国政府は、2月23日に大邱を中心に新型ウイルスの感染者数が急増すると、4段階に分類される感染... -
2020年03月10日
【東南アジア経済】ASEANの貿易統計(3月号)~輸出は欧米向けを中心に減少、新型コロナウイルスの影響は2月以降に反映
20年1月のASEAN主要6カ国の輸出(ドル建て、通関ベース)は前年同月比4.0%減(前月:同... -
2020年03月06日
韓国に経済危機は再来するか?
基礎研REPORT(冊子版)3月号[vol.276]
最近、韓国経済が危ないというニュースが日本のマスコミなどから流れている。一部のマスコミでは19... -
2020年03月04日
インド経済の見通し~成長率は20年1-3月に底打ちするも、低空飛行が続く見通し(2019年度+5.1%、2020年度+5.7%)
インド経済は10-12月期の成長率が+4.7%となり、2013年以来の低成長を記録した。10-... -
コラム2020年02月28日
韓国、車に乗ったまま10分で検査が終わる「ドライブスルー検査」を実施-新型コロナウイルスの新しい検査方法-
新型コロナウイルスの感染が拡大している中で、日本では発熱などの症状があり、検査を希望しても受け... -
コラム2020年02月27日
中国不動産の基本(3)住宅小区
中国の土地は一般的に入札・競売を経て、不動産関係開発業者と地方政府が土地使用権契約を締結するこ... -
コラム2020年02月26日
中国不動産の基本(2)基準地価
中国の土地は「国有」であるため、土地の売買は原則禁じられているが、地方政府による土地使用権の譲... -
2020年02月18日
中国の生命保険市場(2018年版)基礎データ【アジア・新興国】中国保険市場の最新動向(41)
2018年の中国生保市場は、市場の健全化の影響が大きくはたらいた。収入保険料は前年比1.9%増...
片山 ゆき
保険研究部
-
2020年02月17日
【タイGDP】10-12月期は前年同期比+1.6%増~輸出低迷と予算執行の遅れにより、5年ぶりの低成長を記録
2019年10-12月期の実質GDP成長率は前年同期比1.6%増と、前期の同2.4%増から低下... -
2020年02月12日
【マレーシア】10-12月期GDPは前年同期比+3.6%-資源関連が落ち込み、10年ぶりの+3%台の成長に
2019年10-12月期の実質GDP成長率は前年同期比3.6%増と前期の同4.4%増から低下し...
関連カテゴリ
経済予測・経済見通し
829件
日本経済
3261件
個人消費
501件
設備投資
128件
労働市場
603件
家計の貯蓄・消費・資産
760件
米国経済
1453件
欧州経済
1010件
中国経済
717件
研究員の紹介
-

井出 真吾
急上昇した日本株に潜む落とし穴~コロナ禍の成功体験は再現するか~
【株式市場・株式投資・マクロ経済・資産形成】 -

斎藤 太郎
消費者物価(全国25年9月)-コアCPI上昇率は拡大したが、先行きは鈍化へ
【日本経済】 -

天野 馨南子
縮小を続ける夫婦の年齢差-平均3歳差は「第二次世界大戦直後」という事実
【人口動態に関する諸問題】 -

-

-

伊藤 さゆり
ドル離れとユーロ-地位向上を阻む内圧と外圧-
【欧州の政策、国際経済・金融】
コンテンツ紹介
-
レポート
-
受託実績・コンサルティング
お知らせ
-
2025年07月01日
News Release
-
2025年06月06日
News Release
-
2025年04月02日
News Release
アジア・新興国経済のレポート一覧ページです。【シンクタンク】ニッセイ基礎研究所は、保険・年金・社会保障、経済・金融・不動産、暮らし・高齢社会、経営・ビジネスなどの各専門領域の研究員を抱え、様々な情報提供を行っています。
アジア・新興国経済のレポート Topへ

各種レポート配信をメールでお知らせ。
各種レポート配信をメールでお知らせ。



